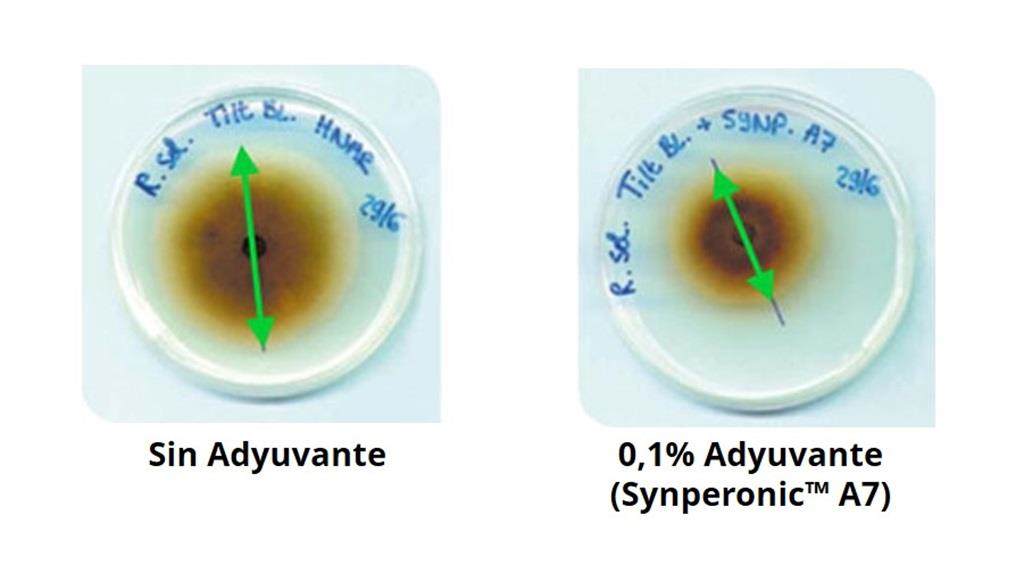

Adyuvantes para fungicidas
Los adyuvantes desempeñan un rol fundamental en el aumento de la eficacia biológica de los agroquímicos. La función de los adyuvantes en las formulaciones herbicidas es relativamente fácil de entender, visto que los herbicidas siempre tienen que penetrar en las males hierbas para ejercer su efecto. Factores fisioquímicos (como adhesión de la aplicación, retención de la aplicación, humectación y esparcimiento) y sistémicos (como la absorción del ingrediente activo) determinan la eficacia de un herbicida.

Sin embargo, la situación de los fungicidas es más complicada. El fungicida puede ser activo contra las esporas fúngicas en la superficie de las hojas y, también, al interior de las células foliares. Además, en muchos casos, su efecto en las esporas fúngicas es de gran importancia. La utilización de un adyuvante introduce un factor adicional a la interacción entre los hongos, el fungicida y la planta huésped. La selección de un adyuvante puede aumentar la penetración y el transporte de la solución de aplicación fungicida en la pared celular de los hongos. Esta interacción entre el fungicida y el adyuvante es lo que determina que se deba elegir un adyuvante específico para cada fungicida y enfermedad fúngica. Desarrollamos una línea de productos específicos para enfrentar los problemas de las formulaciones de fungicidas. Nuestros adyuvantes equilibran dos factores determinantes de la estabilidad de una formulación y de la eficacia del fungicida.
Nuestro más reciente desarrollo en este tipo de tecnología nos ha permitido adicionar Atplus™ PFA a nuestro portafolio de productos. Atplus PFA es un adyuvante vertible que promueve e intensifica la acción de un fungicida principalmente contra la enfermedad de la roya de la soja (Phakopsora pachyrhizi).
El gráfico muestra el desempeño de Atplus PFA en combinación con un fungicida comercial (ingrediente activo: azoxistrobina) para el control de la roya de la soja asiática (Phakopsors pachyrhizi). En ella se puede ver que el uso de Atplus PFA mejora el desempeño del fungicida en términos del porcentaje de hongos que permanecen en la hoja después de que se reduce el tratamiento.
Adyuvantes para Fungicidas
A imagem é um exemplo do efeito de outro adjuvante de nossa gama. Ambas as placas de Petri foram semeadas com micélio de Rhizoctonia solani e tratado com 1ppm de Tilt EC. A placa da direita foi tratada com 0.1% de adjuvante (Synperonic™ A7) enquanto a da esquerda não. O efeito do adjuvante é claro, inibindo o crescimento do fungo em 50%.


